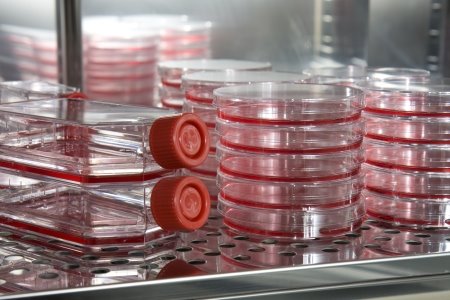

Srbija bi trebalo da krajem 2013. godine dobije banku matičnih ćelija. Na taj način će svi kojima je potrebno lečenje ovim ćelijama moći da besplatno dobiju odgovarajući uzorak iz bilo koje svetske javne banke krvi iz pupčanika. Princip funkcionisanja ove banke je sličan dobrovoljnom davanju krvi - davalac nema kontrolu nad uzorkom, tako da može biti iskorišćen za bilo koga kome je potreban.
Objekat će biti izgrađen u sklopu Instituta za majku i dete i moraće da zadovolji sve standarde propisane za banke krvi iz pupčanika. Kapacitet skladištenja je 10 000 uzoraka.
Sredstva za izgradnju su obezbeđena kroz projekat "Obezbeđivanje uslova za transplantaciju matičnih ćelija hematopoeze kod dece u Srbiji", a planirana ukupna vrednost investicije je 205,8 miliona dinara.